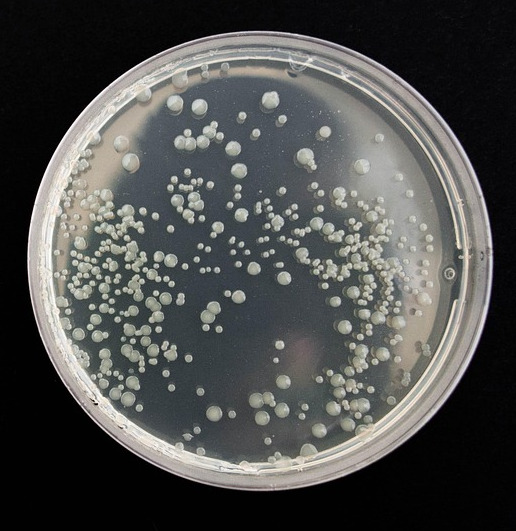
Agro-KapS

Who We Are
SCIOM is a research and development company delivering cutting-edge scientific services at the intersection of ecology, data science, and software engineering.
- Ecological modelling & ecotoxicology
- Remote sensing & satellite data analysis
- AI-powered environmental monitoring
- Custom software & IoT solutions
- GIS & spatial data processing
- Data science training & consulting
Our Services
From field data to actionable insights — we cover the full scientific workflow
Ecological Modelling
Species distribution models, population dynamics, mosquito control optimisation, and ecotoxicology simulations using state-of-the-art algorithms.
Data Analysis
Statistical modelling, pattern recognition, and scientific data processing for research programs, regulatory monitoring, and environmental assessments.
IoT & Sensor Systems
Custom hardware design and data collection systems for real-time environmental monitoring, field research, and automated data pipelines.
Remote Sensing
Habitat mapping from satellite and aerial imagery using deep learning, spectral analysis, and advanced image classification techniques.
GIS
Spatial analysis, habitat mapping, monitoring system design, and interactive geographic data visualisation for environmental management.
Software Development
Web, mobile, and standalone scientific applications tailored for research workflows, data management, field operations, and stakeholder reporting.
Training & Workshops
Data science courses with AI integration — Python, R, Git, and advanced analytics for environmental professionals and researchers.
Consulting
Expert advisory on environmental management, monitoring system design, scientific methodology, and AI integration for research organisations.
Why Choose SCIOM
Science-driven. Results-focused. Truly interdisciplinary.
Interdisciplinary Approach
We combine ecology, computer science, data science, and engineering to deliver solutions no single-discipline team can match — bridging the gap between field science and technology.
Cutting-Edge Methods
From reinforcement learning and deep learning to remote sensing and individual-based models — we use the most advanced tools to solve complex real-world problems.
Proven Track Record
Published in peer-reviewed journals, delivering government-funded projects, and building applications actively used for nature conservation across Croatia and beyond.
Collaborators & Clients
Working alongside leading research institutions, universities, and government agencies
Projects & References
A selection of our recent work across research, government, and industry

Advancing Environmental Monitoring through AI
Open access peer-reviewed chapter in Environmental Resilience and Management — applications of R and Python for ecological monitoring.
Agro-KapS: Bacterial Viability in Concrete
University North — bacterial viability study in pH medium of concrete mix for the Agro Capsules project on reinforced concrete buildings.

Landscape Metrics for Agricultural Habitats
Ministry of Economy — agricultural habitat quality assessment using landscape metrics and spatial analysis tools.

Flora Monitoring System Development
Ministry of Economy — development of monitoring systems for species and habitat types across the Croatian national grid.

Coastal & Marine Habitat Mapping
Ministry of Economy — mapping 30,000+ km² of Croatian coastline and epicontinental belt using remote sensing and field data.

Modelling for Mosquito Population Control
SERRA journal — reducing contamination risk from mosquito population control through stochastic ecological modelling.

ECEM 2023 Presentations
4 presentations at the European Conference on Ecological Modelling — mosquito population models, remote sensing integration, ecotoxicology, and IBM simulations.

ISEM 2023 Presentations
2 presentations at the International Society for Ecological Modelling Global Conference — AI-powered mosquito control platforms and reinforcement learning for SIT optimisation.
Ready to start your project?
Whether you need a one-time analysis or a long-term research partner, we would love to hear about your challenge.
Let's TalkContact
We look forward to cooperation and new achievements!
Headquarters
Fruškogorska ulica 5
HR-31000 Osijek, Croatia
VAT: HR45037543610
BIOS
Ulica Josipa Jurja Strossmayera 341
HR-31000 Osijek, Croatia
Mon–Fri, 9:00–17:00
Office — Ulica Josipa Jurja Strossmayera 341 (BIOS)









